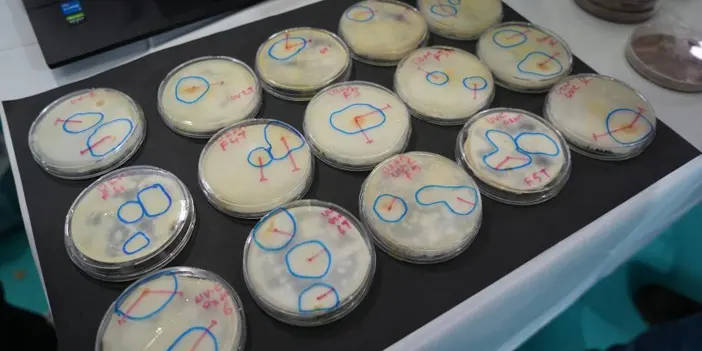
bulus4.webp

Samsun’da lise öğrencilerinden önemli buluşlar!
Samsun’da düzenlenen "Lise Öğrencileri Araştırma Projeleri Bölge Yarışması", lise öğrencilerinin bilimsel ve yenilikçi projelerini sergilemeye devam ediyor. Ondokuz Mayıs Üniversitesi (OMÜ) ev sahipliğinde gerçekleştirilen yarışmada, Samsun ve Ordu’dan öğrenciler önemli projelere imza attı.
Otonom Ortam Sterilizasyon Sistemi Geliştirildi
Samsun Atakum Bilim Sanat Merkezi öğrencileri Yaşar Yiğit Toraman, Kerem Bekdemir ve Nevin Emek Avcı, kapalı ortamları sterilize edebilen "Otonom Ortam Sterilizasyon Sistemi" adlı bir proje geliştirdi.

Öğrenciler, geliştirdikleri cihazda UVC radyasyonu ve ozon gazının antimikrobiyal özelliklerini kullanarak temassız ortam sterilizasyonu sağlıyor. Proje hakkında bilgi veren Yaşar Yiğit Toraman, cihazın insan algılama sistemi sayesinde, çalışma esnasında odaya biri girdiğinde otomatik olarak durduğunu belirtti.
Projenin hastaneler, poliklinikler, ameliyathaneler ve MR odalarında kullanılabileceğini ifade eden Toraman, cihazın 40 dakika içerisinde ortamı tamamen sterilize edebildiğini söyledi. Piyasada sadece ozon jeneratörünün 18-20 bin TL maliyeti olduğu belirtilirken, geliştirilen cihazın UVC sistemi, ozon sistemi ve insan algılama sistemini içeren tüm mekanizmasıyla toplamda 25 bin TL maliyetle üretildiği ifade edildi.

Ordu'da Öğrenciler Odun Külünden Sirke Üretti
Ordu’da özel bir lisede eğitim gören Bilgenur Altun ve Dilay Ceren Çekver, odun külünden sirke üretimi yaparak kedi kumunu daha hijyenik hale getirmeyi amaçlayan bir proje geliştirdi.
Odun Külü Sirke Üretim Süreci
Proje hakkında bilgi veren Dilay Ceren Çekver, odun külünü sirkeye dönüştürme sürecini şöyle anlattı:
"Odun külümüzü değirmende çektirdik, ardından sıcak meşe odununu elma suyu ile birleştirdik. Üzerine kaya tuzu ve bal ekleyerek 6 ay beklettik ve doğal sirke elde ettik."
Öğrenciler, ürettikleri bu sirkeyi kedi kumunda kullanarak hijyen seviyesini artırmayı amaçladıklarını ifade etti.

Odun Külü Sirkesi Alternatif Tıpta Kullanılabilir mi?
Bilgenur Altun ise odun külü sirkesinin antibakteriyel özellik gösterdiğini ve alternatif tıp açısından değerlendirilebileceğini belirtti. Sirkenin göbek bölgesindeki yağları eritme, grip ve damar tıkanıklığı gibi rahatsızlıklara iyi gelme potansiyeli olduğuna dair duyumlar aldıklarını ifade eden Altun, bu konuda daha fazla araştırma yapılması gerektiğini vurguladı.
Kaynak:

